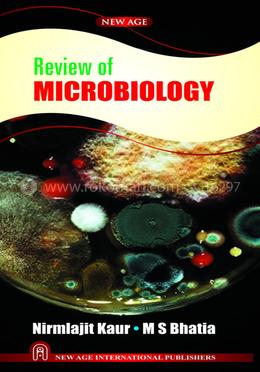
Review of Microbiology

রকমারিতে স্বাগতম!
Recently searched ![]()
Popular right now
সাধারণ জ্ঞান Smart Watch Calculator Skin Care Hair Care QNA publications আর রাহীকুল মাখতুম Trimmer এক নজরে কুরআন প্যারাডক্সিক্যাল সাজিদ Osufi serum আমৃত্যু ভালোবাসি তোকে অপেক্ষা হুমায়ূন আহমেদ Smart watch খায়রুলস বেসিক ম্যাথ Casio watch ভালো নেই ভালোবাসা অদৃশ্য অসুখ তুমি Casio fx-991ex Dr Rashel vitamin c serum এসো আরবি শিখি তুমি সন্ধ্যা অলকানন্দা Crack previous mcq গল্পের বই বিষাদের আয়ু তিন প্রহর Job solution বাঙালির জয় বাঙালির ব্যর্থতা লেকচার গাইড নফসের বিরুদ্ধে লড়াই Professor job solution অগ্রদূত বাংলা হুমায়ূন আহমেদ

 Hello, Sign in
Hello, Sign in 
 Cart
Cart